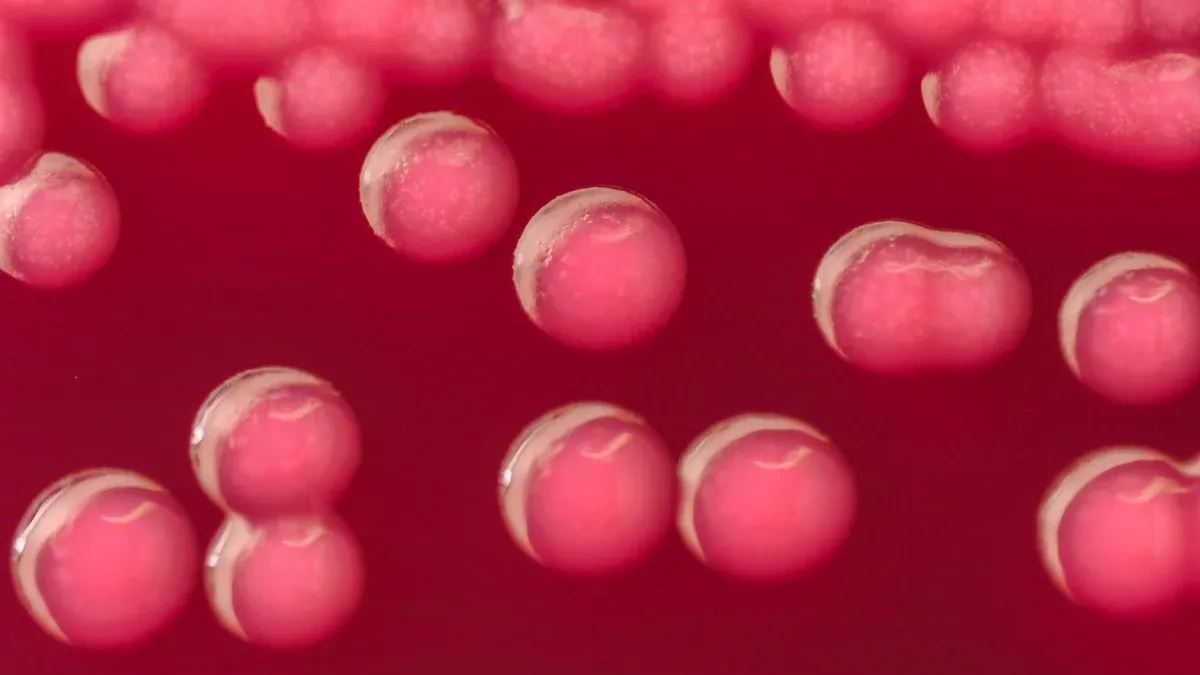
Horse Blood Types Overview

Horses have eight major blood groups, which leads to approximately 400,000 distinct blood types. This vast variety makes understanding horse blood types crucial for you as a horse owner or veterinarian. Knowledge of blood type compatibility is essential, especially during transfusions. Mismatched blood can cause serious health issues in horses. By knowing the blood types, you can ensure better health and safety for your equine companions.
Key Takeaways
Understanding horse blood types is crucial for safe blood transfusions and overall equine health.
Always perform blood type compatibility testing before transfusions to prevent serious health issues.
Utilize methods like cross-matching to ensure donor and recipient blood types match.
Regular blood type testing helps identify suitable donors, reducing risks during emergencies.
Consult your veterinarian for guidance on blood type testing and transfusion protocols.
Horse Blood Types Overview
Complexity of Blood Types
Horses have eight major blood groups that define their blood types. These groups are:
A
C
D
K
P
Q
U
T
Among these, groups A, C, and Q hold particular importance. They play a significant role in the development of alloantibodies. Alloantibodies are antibodies that horses produce against foreign blood group antigens. Horses do not naturally create these antibodies unless they encounter a different blood type. This exposure often occurs during blood transfusions or through transplacental hemorrhage at birth.
Understanding these blood types is crucial for managing equine health. For instance, if a mare and her foal have incompatible blood types, it can lead to neonatal isoerythrolysis (NI). This condition arises when the foal inherits a red cell factor from its sire that the mare lacks. The mare may then produce antibodies against this factor. While these antibodies do not harm the foal during pregnancy, they can be transferred through colostrum after birth. This transfer can result in the destruction of the foal’s red blood cells, leading to serious health issues.
To summarize, the complexity of horse blood types and their associated antibody responses is vital for ensuring safe blood transfusions and overall equine health.
Blood Transfusions in Horses

Blood transfusions can be life-saving for horses, but they come with significant risks if not managed properly. Understanding these risks is essential for you as a horse owner or veterinarian.
Risks of Mismatched Transfusions
Compatibility testing is crucial before any blood transfusion. You must ensure that the donor and recipient blood types match to avoid serious complications. Mismatched transfusions can lead to various adverse reactions, which can range from mild to severe.
Here are some common clinical signs that may occur after a mismatched blood transfusion:
Clinical Sign | Occurrence in Transfusions | Notes |
|---|---|---|
Mild fever | 6/8 | Defined as >1°C increase from baseline, lasting up to 2 days. |
Tachycardia | 7/8 | Heart rate increased to 48–60 beats/min. |
Urticaria or pruritis | 3/8 | One case treated with diphenhydramine. |
Tachypnea | 2/8 | Increased respiratory rate noted. |
Sweating and muscle fasciculations | 1/8 | Observed during transfusion. |
Transient systolic murmur | 1/8 | Cardiac auscultation revealed a temporary murmur. |
Arrhythmia | 2/8 | Irregular heart rhythm noted. |
Mild icterus | 3/8 | Slight yellowing of mucous membranes observed. |
Severe hemolysis | 0/8 | No evidence of severe hemolysis within the first 5 days post-transfusion. |
Anaphylactic reactions | 0/8 | No cases of anaphylaxis reported. |

The absence of a universal donor blood type in horses complicates transfusion practices. Unlike some other species, horses have multiple blood types, which increases the risk of incompatibility. Here are some key points regarding this issue:
The variety of horse blood types contributes to the lack of a universal donor.
Environmental factors can influence the development of alloantibodies, making transfusion compatibility more complex.
Certain breeds, such as Straight Egyptian Arabian horses, may serve as better donors in emergencies due to their lower incidence of alloantibodies.
Testing for Blood Compatibility
Testing for blood compatibility is essential for safe blood transfusions in horses. You can use several methods to determine compatibility between donor and recipient blood types. The two primary methods are blood typing and cross-matching.
Blood Typing Methods
Blood typing identifies the specific blood group of a horse. Here are some common methods used:
Method Type | Description | Accuracy |
|---|---|---|
Tube Agglutination (TUBE) | Standard method for cross-matching and blood typing | Excellent accuracy for agglutination (AUC-ROC = 0.912) |
Gel Column (GEL) | Alternative method with good accuracy for agglutination | Excellent accuracy (AUC-ROC = 0.903) but marginal for hemolysis (AUC-ROC = 0.639) |
Immunochromatographic Strip (STRIP) | Novel point-of-care method for blood typing | Hypothesized to be accurate for Ca blood typing, with good compatibility evaluation |
These methods help you determine the horse blood types and ensure compatibility before a transfusion.
Cross-Matching
Cross-matching is another critical step in ensuring safe blood transfusions. This process assesses compatibility between the donor and recipient horses. It involves testing the immunological reactivity of blood samples from both horses. The major cross-match evaluates the recipient’s serum against the donor’s erythrocytes. This evaluation provides insights into potential transfusion reactions and the survival time of the transfused cells.
Tip: Always perform cross-matching before a transfusion. This step is vital for preventing transfusion reactions, which can lead to serious health issues.
Understanding the role of major red blood cell antigens is crucial in this process. These antigens can trigger the production of alloantibodies in the recipient horse if they encounter foreign blood types. Therefore, knowing the blood group of both the donor and recipient helps you avoid complications during a whole blood transfusion.
Understanding horse blood types is vital for effective health management and safe transfusion practices. Here are some key takeaways for you as a horse owner:
Blood type compatibility prevents adverse reactions during transfusions.
Testing methods, such as cross-matching, are essential to determine compatibility before transfusions.
The gel column method is faster and requires less blood than traditional tube methods, making it practical for clinicians.
Regular blood type testing allows veterinarians to identify blood group antigens in potential donors ahead of time. This ensures that selected donors match the recipient’s blood type, reducing the risk of adverse reactions in emergencies.
Tip: Always consult with your veterinarian regarding blood type testing and transfusion protocols to ensure the best care for your horse.
Product | Volume | Frequency | Indications |
|---|---|---|---|
Fresh whole blood | 12 to 20 ml/kg | q. 24 h | anemia, platelet & factor replacement |
Packed red cells | 6 to 10 ml/kg | q. 12 to 24 h | anemia |
Platelet rich plasma | 6 to 10 ml/kg | q. 8 to 12 h | platelet dysfunction, thrombocytopenia |
Fresh and fresh frozen plasma | 6 to 12 ml/kg | q. 8 to 12 h | coagulation factor deficiencies, vWD, DIC, hypoproteinemia |
Frozen plasma | 6 to 12 ml/kg | q. 8 to 12 h | hypoproteinemia |
Plasma cryoprecipitate | 1 unit/10 kg | q. 4 to 12 h(as needed) | hemophilia A (factor VIII deficiency), fibrinogen deficiency, von Willebrand disease |
Cryosupernatant | 6 to 12 ml/kg | q. 8 to 12 h | hemophilia B (factor IX deficiency), factor VII, X, or XI deficiency, vitamin K deficiency, hypoproteinemia |

By prioritizing blood type knowledge, you can enhance the health and safety of your equine companions.
FAQ
What is neonatal isoerythrolysis in horses?
Neonatal isoerythrolysis occurs when a foal inherits a blood type from its sire that the mare lacks. The mare produces antibodies against this foreign blood type, which can harm the foal after birth.
How can I test my horse’s blood type?
You can test your horse’s blood type through blood typing methods like tube agglutination or gel column tests. These methods help identify the specific blood group of your horse.
Why is cross-matching important before a transfusion?
Cross-matching is crucial because it assesses compatibility between the donor and recipient. This step helps prevent adverse reactions during blood transfusions, ensuring your horse’s safety.
Can all horses receive blood transfusions?
Not all horses can receive blood transfusions safely. Each horse has a unique blood type, so compatibility testing is essential to avoid serious health issues.
What should I do if my horse needs a transfusion?
If your horse needs a transfusion, consult your veterinarian immediately. They will perform blood typing and cross-matching to ensure a safe and effective transfusion.

